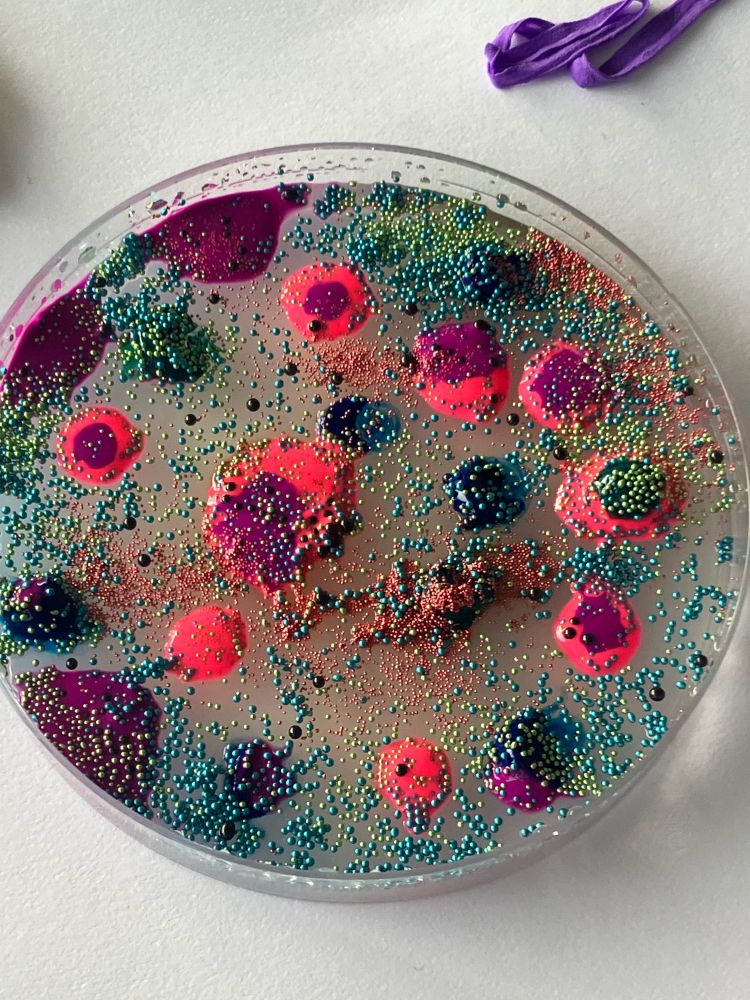
Post image

#collage
17.12.2024 15:05 — 👍 2 🔁 0 💬 0 📌 0

Little play with collage… spot the signs of life 🏠 #collage #analoguecollage
19.11.2024 14:51 — 👍 7 🔁 0 💬 1 📌 0
Optimist. Interested in everything. Asks awkward questions.
Artist and nerd. Surprisingly tall.
Felicityinkpen.co.uk
Instagram.com/felicityinkpen
https://substack.com/@felicityinkpen
Art - Environmental Humanities - Biophilosophy. Transversal dialogues. Connects artists, artistic researchers and other practitioners 🌻Web: https://ecobioartlab.net/
Film Artist. https://linktr.ee/TrixStarT
TrixStarT.com Film Props. Movie Maker. Dem. Wabi-sabi. Epicurean. Stoic.
Ant-lover, drummer
lisaschonberg.com
PhD Candidate at Netherlands Cancer Institute〡Structural Biology〡Experimental–Computational Integration〡
Curious about AI-Integrated Biology and Synthetic Biology 🔬〡
Bioillustration using Blender🧬〡
🇪🇸 🇳🇱
https://beacons.ai/rborza
Plant-environment interactions | Arabidopsis |MIBTP PhD student University of Warwick| Master's alumnus at IISER Kolkata| Avid Fantasy reader
Tenured Researcher on Computational Systems Biology
Institute for Integrative Systems Biology (@i2sysbio.bsky.social), @csic.es
visitor at @bsc-cns.bsky.social, @alfonsovalencia.bsky.social team
also at @arnaumontagud@fediscience.org
University of Florida | SYBORGS Lab 🧬 🦠
PhD Student | synbio / biomanufacturing / space |
all views are my own
Award winning tabletop game designer & formalist poet. Woke vegetarian gun owner. Zen mootist. "Retired."
Angry lefty. Devoted Dad. Tattooer/ Illustrator and massive kustom nerd.
WEAD is a network of feminist ecoartists, educators, curators, and writers working toward the goal of a just and healthy world. We focus on women’s unique perspective in ecological and social justice art.
Artist/Roboticist/Animal. I build robots for animals and the landscapes and systems they live within. I also lead the Conservation Technology Lab at the San Diego Zoo Wildlife Alliance. www.ianingram.org
Art critic, curator and forever blogger https://we-make-money-not-art.com/
Interdisciplinary artist, working with & critiquing emerging technologies, with a focus on technologies of life. Critical Theory professor, Co-director of Bioart Ethical Advisory Kommission. More at https://www.prabapilar.com
#dataviz enthusiast & interactive storyteller. Building visual essays, dashboards, and tech projects.
Pro sectors: electronics, semiconductors.
More at ThisIsJam.es
I run the Info Vis Group in Barcelona:
www.infovisgroup.org
Amor Mundi Institute & Amor Mundi Lab Director, academic/scholar, eco-political theorist, speculative storyteller, eco-ethnographer, curator,
Resist the Anthroposupremocene, nurture symbiopoiesis, & re-imagine human praxis in a more-than-human world